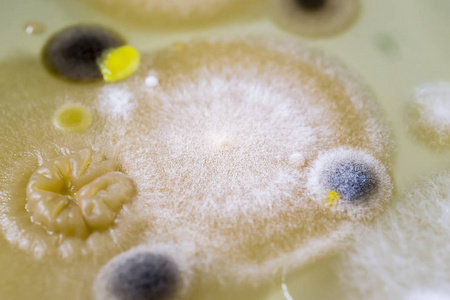
真菌菌落图片

细菌真菌图片

8】细菌,真菌观察培养——黑格尔老师带你开启微生物世界-在线订票
图片尺寸800x529
真菌,细菌的观察
图片尺寸1338x1024
杆菌枯草杆菌,绿豆积极的细菌,用过的同样地真菌剂向照片
图片尺寸450x300
狗狗真菌,细菌,教你如何区分|处理7515.
图片尺寸1440x1920
细菌.真菌.病毒三者之间有什么区别?
图片尺寸854x551
真菌细菌图片
图片尺寸450x300
大讲堂真菌图片小札(一)
图片尺寸999x1332
转载硅胶厂家带您认识真菌细菌病毒的区分
图片尺寸1066x788
产生真菌毒素的真菌镰刀菌细菌细胞设置真菌头发化学和细胞因子参与
图片尺寸450x300
引起疾病的微生物对象,不同类型, 细菌, 病毒, 真菌, 原生动物
图片尺寸480x300
真菌菌落图片
图片尺寸323x300
细菌,真菌,病毒属不属于分子?
图片尺寸1024x731
真菌菌落图片
图片尺寸450x300
细菌 真菌 病毒 曾琳玲
图片尺寸1080x810
真菌细菌图片
图片尺寸453x300
真菌
图片尺寸383x450
"阿莫西林"要认清,旨在5种病有效,乱用,滥用或会引火烧身
图片尺寸2100x1400
细菌,真菌,病毒的特点
图片尺寸1220x1062
多年生真菌图片
图片尺寸450x300
微生物的神奇世界:发现隐藏的王国|细菌|真菌|植物|生物技术_网易订阅
图片尺寸660x364